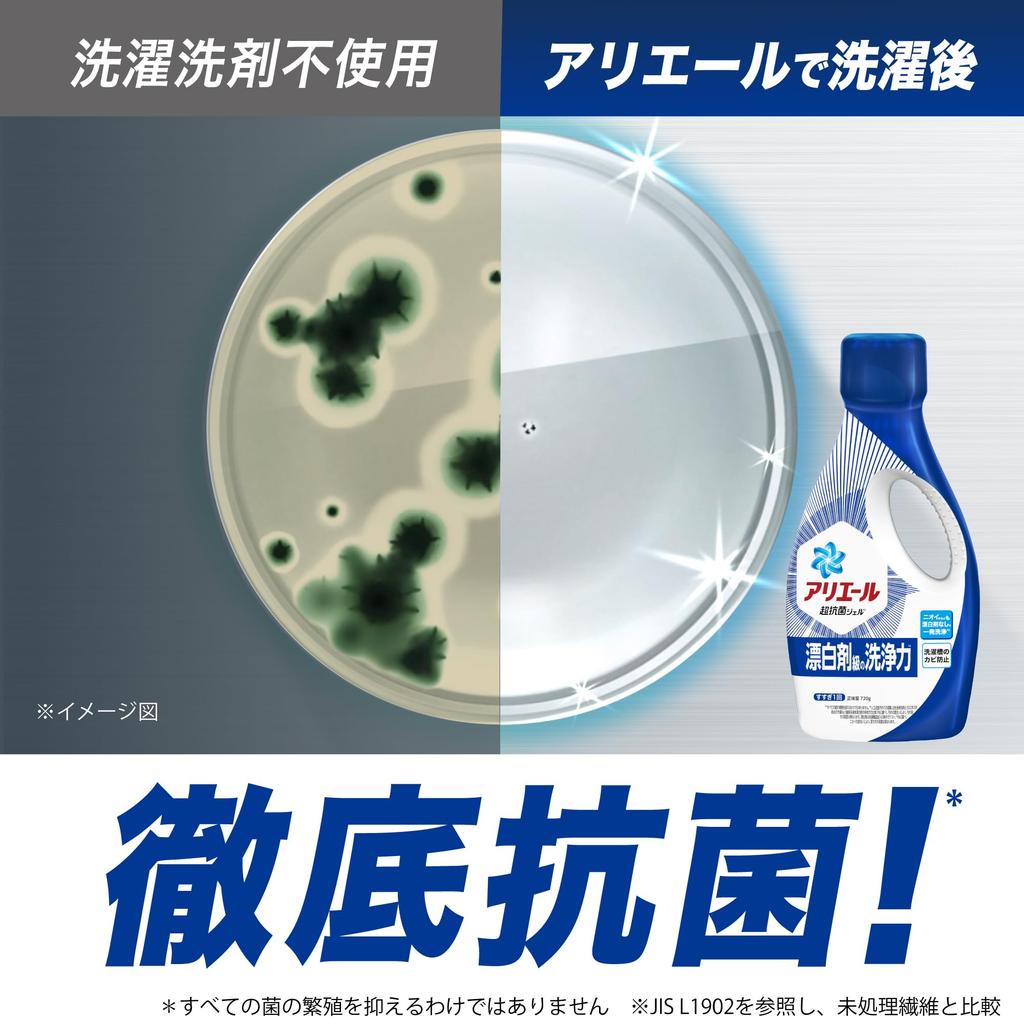
Жидкий стиральный порошок Ariel, сменный блок, большая емкость, 3,03 кг

премьера продукта
Жидкий стиральный порошок Ariel, сменный блок, Мега-Джамбо размер, 3,03 кг
Стиральный порошок + Моющая сила уровня отбеливателя* Удаляет пожелтение и запахи за один раз, без отбеливателя*1
Предотвращает образование плесени в барабане стиральной машины
Совместимо с вертикальной и фронтальной загрузкой
Тщательное антибактериальное*2
Один цикл полоскания
Предотвращает пожелтение, стойкие запахи и плесень в барабане стиральной машины: Решение трех основных проблем с стиркой
*Протестировано на искусственных пятнах кожного сала. Сравнение нашего жидкого моющего средства с лидирующим на рынке жидким отбеливателем на основе кислорода (по состоянию на март 2022 г.) (исследования P&G). Эффективность удаления пятен зависит от степени загрязнения. Отбеливатель тестировался в условиях прямой нагрузки.
*1 По данным исследования P&G. Эффективность удаления зависит от степени загрязнения и запаха. *2 Не подавляет рост всех бактерий.
Ингредиенты
ПАВ (26%: Полиоксиэтиленовый эфир спирта, линейный алкилбензолсульфонат, чистое мыло (соль жирной кислоты)), стабилизатор, щелочь, диспергатор, смягчитель воды, оптический отбеливатель, фермент
Моющее средство + чистящая сила уровня отбеливателя в одном флаконе. Обновленная Ариэль решает три проблемы одновременно: удаление пожелтения, устранение запаха сырости и предотвращение образования плесени в барабане стиральной машины.
Чистящая сила уровня отбеливателя в одном флаконе. Удаляет стойкое пожелтение и предотвращает появление плесени в барабане стиральной машины для тщательного устранения запаха.
Мощное моющее средство тщательно удаляет даже пожелтения с рубашек и подушек, оставляя их сверкающе белыми только с помощью стирального порошка.
Обновленный Ariel мгновенно устраняет запахи сырости и тщательно дезинфицирует белье.
Предотвращает образование плесени и тщательно дезодорирует барабан стиральной машины. Защитная от капель крышка эффективно предотвращает эти надоедливые капли.
 Товар из Японии
Товар из Японии

![Жидкий стиральный порошок Ariel, сменный блок, 1,91 кг + Дополнительный объем, Моющая сила уровня отбеливателя [Большой объем] [Совместим с вертикальными и фронтальными стиральными машинами]](https://img-edg.joomcdn.net/75e56410069d67db567006d92e87ba477ac442d6_100_100.jpeg)



![Humming Дезодорирующий Тканевый Идеально подходит для стирки и сушки Непревзойденный Антибактериальный Аромат Белого Мыла [Большой Объем] Кондиционер. полная нагрузка в помещении.](https://img-edg.joomcdn.net/dd421354a54951b0e66b29117c8ab05c6870d9f6_100_100.jpeg)

![Ariel Laundry Detergent Gel Ball PRO Refill 110 шт. x 3 пакета [Большая емкость] [Коробка для продукта]](https://img-edg.joomcdn.net/34362e3045f4bcfbcaef5309f7004842c49da00a_100_100.jpeg)
![Ariel Стиральный порошок гель шариковый Pro Power Super Clean Fresh Scent сменный блок 87 штук антибактериальный/чистящий [большая емкость]](https://img-edg.joomcdn.net/52a084421333e4e101cc889d1662fb9f57ffee19_100_100.jpeg)




![CuCute Средство для мытья посуды Прозрачный дезинфицирующий наполнитель 1380 мл [Большая емкость]](https://img-edg.joomcdn.net/58479473bfb1d354962479cf04135661b0f85d3b_100_100.jpeg)
![Ariel MiRAi Laundry Высший уровень очищения для и 1170г Сверхконцентрированный стиральный порошок - Воротники, Рукава, Тусклость - Сменный блок, [Большой объем]](https://img-edg.joomcdn.net/a17c7e9dda9d5a203f77b6f611d773cd4f86da30_100_100.jpeg)
![Ariel MiRAi Laundry для сушки в помещении и спорта 1170 г Стиральный порошок, Ультраконцентрированный Компактный, Использование, Заправка, [Большой объем]](https://img-edg.joomcdn.net/4493e4be6bebb784978c8caa3a49c68cb611c151_100_100.jpeg)
![Гель-шарики для стирки Ariel PRO, сменный блок, 110 штук [Большой объем]](https://img-edg.joomcdn.net/d14ed1c022f0a30849e88cd51049b40605125efd_100_100.jpeg)
![Ariel Стиральный порошок гель шариковый Pro Полная очистка дезодорирующий чистый и освежающий аромат сменный блок 100 штук [большая емкость]](https://img-edg.joomcdn.net/9ca87f67f122bcd13e4e9ccb7b90e83da7eaf0a4_100_100.jpeg)

